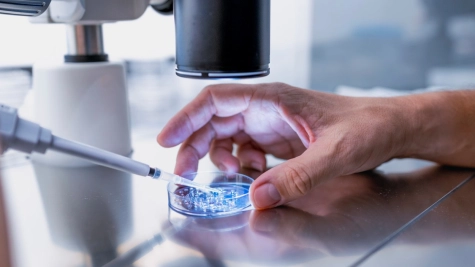

Our publications
Our publications
Group publications


The New Rules on Beneficial Ownership Declaration
Learn the updated SEC Beneficial Ownership Disclosure Rules (2026) in the Philippines, including new reporting thresholds, disclosure requirements, and penalties for non-compliance.

APAC Corporate secretarial newsletter 2025 issue 2
As companies expand into new international markets, they unlock new opportunities but also face increased compliance risks. Asia Pacific (APAC), a key driver of global economic growth, is an attractive destination for multinational companies looking to grow. However, each country within the region has its own unique regulations, making compliance a complex task for businesses of all sizes. To help...
C-suite barometer: life sciences & pharmaceuticals
In a year marked by global uncertainty, shifting regulations, and fast-moving innovation, leaders in the life sciences & pharmaceuticals sector are redefining their strategic priorities.

APAC Corporate secretarial newsletter 2025 issue 1
As businesses expand their operations into new countries, it brings a wealth of opportunities but also creates compliance risks. With its economies driving global growth, Asia Pacific (APAC) is an inviting region for multinational corporations seeking expansion. Each jurisdiction in the region has its own rules and regulations so getting compliance right is a challenge faced by businesses of all sizes....

Forvis Mazars Quarterly Newsletters
You will find here all the published newsletters released by Forvis Mazars.

APAC payroll newsletter 2024 Vol.4
Our APAC payroll newsletter helps provide important updates on the latest regulatory changes and best practices that have influenced payroll operations in the APAC region over the past quarter. Our commitment is to keep you well-informed and empowered in navigating the evolving payroll sector.

VAT on Digital Services Provider
The Philippines has issued a new legislation, Republic Act No. 12023, imposing a 12% value added tax (VAT) on digital services. Under the new law, suppliers of digital services, whether resident or non-resident, shall be liable for assessing, collecting, and remitting the VAT on the digital services consumed in the Philippines, subject to the provision on withholding of VAT.

Doing business in Asia Pacific 2024-2025
The Asia Pacific region plays an important role as a driver of the global economy. As international businesses seek to expand overseas, the region offers some of the best opportunities for growth. This guide has been prepared to assist those interested in doing business in Asia Pacific. It does not cover the subjects it treats exhaustively, but is intended to answer some of the important broad questions...

Doing Business in the Philippines Guidelines
This guide from Forvis Mazars showcases the features, functions, and procedures that would improve your capacity on doing business in the Philippines.

Growing Global
Meeting the compliance challenges of an increasingly complex business world

Set for growth: our story
In recent years, businesses, individuals and governments have encountered a succession of demanding circumstances, prompting the need for resilience, heightened adaptability, and strategic planning amid ongoing uncertainty. In face of this, Forvis Mazars is set to look to the future with a clear and forward-thinking vision to support our clients, people and communities in seizing opportunities for...

Set for growth: 2022/2023 annual report
In recent years, businesses, individuals and governments have encountered a succession of demanding circumstances, prompting the need for resilience, heightened adaptability, and strategic planning amid ongoing uncertainty. In face of this, Forvis Mazars is set to look to the future with a clear and forward-thinking vision to support our clients, people and communities in seizing opportunities for...

APAC payroll newsletter 2024 Vol.1
26 February 2024 Our APAC payroll newsletter helps provide important updates on the latest regulatory changes and best practices that have influenced payroll operations in the APAC region over the past quarter. Our commitment is to keep you well-informed and empowered in navigating the evolving payroll sector.

Forvis Mazars C-suite barometer: outlook 2024
Our annual C-suite barometer gathers the views of leading executives from all over the world. With insights from around 800 executives across 30 countries, we uncover the strategic priorities on the C-suite’s agenda and the market trends and transformations expected to impact businesses in the years ahead. Our latest study reveals that 2024 is set to be a bounce forward year: a year of increasing...

SEC eSPARC online business registration
28 December 2023 This guide showcases the Electronic Simplified Processing of Application for Registration of Company (eSPARC), the Securities and Exchange Commission’s (SEC) new online facility catering to the application for registration of One Person Corporations (OPC) and Domestic Corporations (Both Stock and Non-stock). Online business registration Forvis Mazars Corporate Secretarial services.

Sustainability practices stocktake
Financial institutions have a leading role to play in shaping our sustainable future, and a strong need to reboot and shift to a more responsible finance model. As a core component of the economy, they bear the responsibility of upholding rigour and resilience in their risk management. With time running out to achieve a move towards nature-positive outcomes, what sustainability progress have banks...
Future-proofing cyber security
In a world that has become reliant on digital technology, most organisations’ current cyber security strategies are no longer enough to combat threats. Future-proof your business by understanding and mitigating cyber risks.

Sustainable, smart, and synchronised
Mature markets are experiencing a shift in consumer demand patterns as consumers move away from traditional products and services towards those consistent with environmental, social, and governance goals. Our study ‘Sustainable, smart, and synchronised’ explains how consumer companies can harness ESG and digital transformation to thrive in this changing environment.

APAC C-suite barometer 2023
Following three years of pandemic woes, the world is finally transitioning to normalcy. In Asia Pacific (APAC), the positive effects of the transition have been palpable. While there is no shortage of challenges, including inflation and high energy costs, APAC executives are confident of their growth prospects in the near future. They are proactively taking steps to tackle ongoing challenges, while...

Public and social sector study 2023
20 June 2023 The public and social sector is in a time of transformation. Expectations of organisations in the sector are higher than ever while financial constraints and regulatory burdens are increasing.

Forvis Mazars for good: Sustainability report 2022
Sustainability is at the heart of our business at Forvis Mazars, and to honour this, for the fourth consecutive year, we have released our 2022 sustainability report, which reflects our commitment in action.

M&A in APAC 2023 webinar
The Asia Pacific region has emerged as a prime destination for M&A activities. But navigating the complexities of M&A transactions in diverse APAC markets can be challenging.


